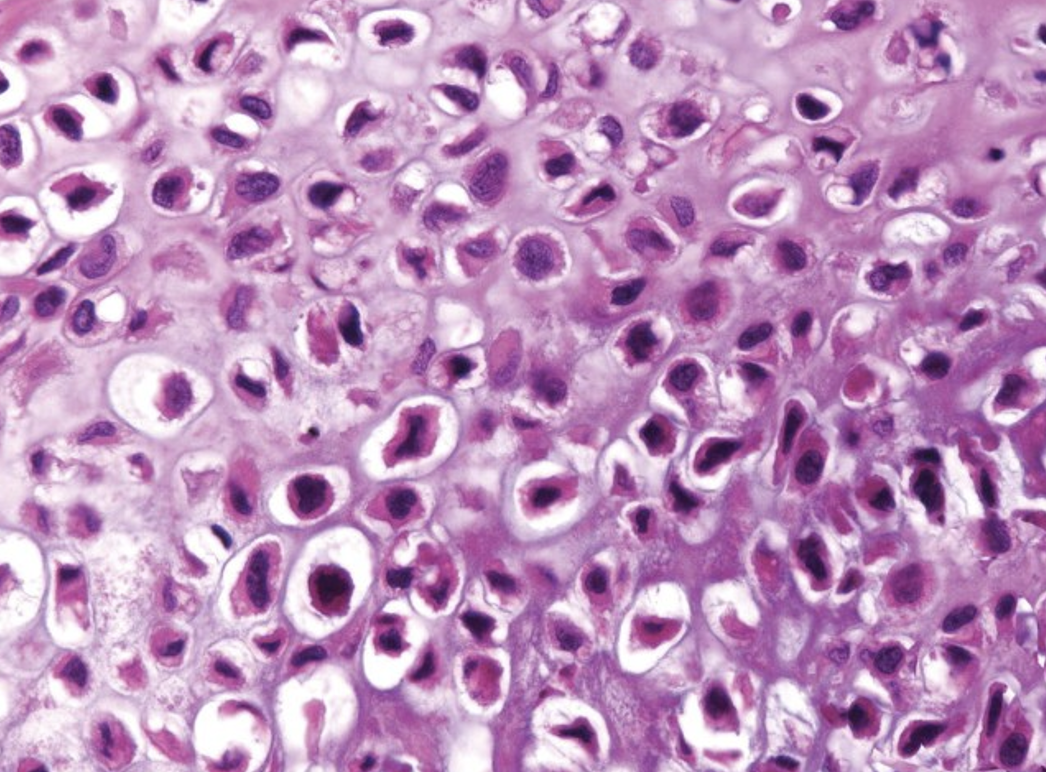
<p><span>Describe the gross appearance.</span></p><p style="text-align: left;"><span>What is the cell of origin?</span></p><p style="text-align: left;"><span>What is the diagnosis?</span></p><p style="text-align: left;"><span>What is the malignant counterpart called?</span></p>

1/16
Looks like no tags are added yet.
Name | Mastery | Learn | Test | Matching | Spaced | Call with Kai |
|---|
No study sessions yet.
yellow fatty surface/round circum
adipose tissue
lipoma
liposacroma
Mesenchymal neoplasms
Describe the gross appearance.
What is the cell of origin?
What is the diagnosis?
What is the malignant counterpart called?

yellow fatty surface/round circum
adipose tissue
lipoma
liposacroma
Mesenchymal neoplasms
Describe the gross appearance.
What is the cell of origin?
What is the diagnosis?
What is the malignant counterpart called?

well circum smooth muscles
lyomyoma
lyosarcoma
Mesenchymal neoplasms
Describe the gross appearance.
What is the cell of origin?
What is the diagnosis?
What is the malignant counterpart called?

well circum smooth muscles
lyomyoma
lyosarcoma
Mesenchymal neoplasms
Describe the gross appearance.
What is the cell of origin?
What is the diagnosis?
What is the malignant counterpart called?

bone
more stroma/ mass lesion»»»new growth
chondoma
chondosarcoma
Mesenchymal neoplasms
Describe the gross appearance.
What is the cell of origin?
What is the diagnosis?
What is the malignant counterpart called?

bone
more stroma/ mass lesion»»»new growth
chondoma
chondosarcoma
Mesenchymal neoplasms
Describe the gross appearance.
What is the cell of origin?
What is the diagnosis?
What is the malignant counterpart called?

chondrosarcomma
less stroma
will circum shape
border well defined
nuclei larger
polymorphism
infiltration adjacent bones
Mesenchymal neoplasms
Describe the gross appearance.
What is the cell of origin?
What is the diagnosis?
What is the malignant counterpart called?

chondrosarcomma
less stroma
will circum shape
border well defined
nuclei larger
polymorphism
infiltration adjacent bones
Mesenchymal neoplasms
Describe the gross appearance.
What is the cell of origin?
What is the diagnosis?
What is the malignant counterpart called?
adinoma
benign because no invasion
benign epithelial neoplasm (glandular)
mucin decrease
may lead to adenocarcinoma
Describe the gross appearance.
What is the cell of origin?
What is the diagnosis?
What is the clinical significance?

adinoma
dysplasia\
benign epithelial neoplasm (glandular)
may lead to adenocarcinoma
Describe the gross appearance.
What is the cell of origin?
What is the diagnosis?
What is the clinical significance?

papilloma
خط يؤدي إلىsquamous cell carcinoma
benign epithelial neoplasm (squamous)

papilloma
خطر squamous cell carcinoma
benign epithelial neoplasm (squamous)

papilloma
خطر squamous cell carcinoma
benign epithelial neoplasm (squamous)

adenocarcinoma
malignant epithelial neoplasm (glandular)
necrosis/ulceration
pale /brown
infiltration into surrounding tissues

adenocarcinoma
malignant epithelial neoplasm (glandular)
invading into wall of bowel
irregular growth

malignant epithelial neoplasm (glandular)

squamous cell carcinoma in lung
malignant epithelial neoplasm (squamous)
infiltrATION_ IRREGULAR
